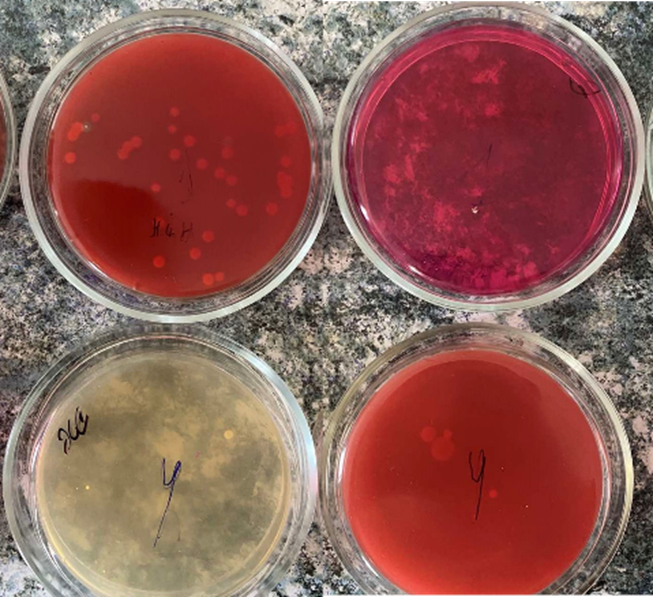

Наукові лабораторії інституту
Наукова робота інституту передбачає планування та виконання дисертаційних, науково-дослідних робіт, організацію та участь у проведенні всеукраїнських і міжнародних наукових форумів, забезпечення роботи лабораторії мікробіологічних і паразитологічних досліджень.
В ННІ медико-біологічних проблем створені дві наукові лабораторії: на кафедрі фізіології з основами біоетики та біобезпеки та кафедрі мікробіології, вірусології та імунології.
У лабораторії психофізіологічних досліджень, яка знаходиться на кафедрі проводилися дослідження згідно планової наукової роботи кафедри «Психофізіологічні аспекти пристосування молодих осіб в умовах глобального потепління» .
У березні 2003 р. була створена Лабораторія мікробіологічних і паразитологічних досліджень, яка пройшла державну акредитацію та отримала Акт на право проведення методик вимірювань.

Лабораторія мікробіологічних і паразитологічних досліджень
Сферами наукових інтересів колективу лабораторії є мікробна екологія людини в різні вікові періоди в нормі та при патології; адгезивні, антагоністичні, антикомплементарні властивості мікроорганізмів; антибіотикочутливість бактерій; вплив мікроорганізмів на розвиток соматичних захворювань; проблеми застосування пробіотиків у медицині, гельмінтози. У лабораторії проходить санітарно- профілактичне обстеження працівників та здобувачів01 всіх факультетів університету, що включає понад 6000 бактеріологічних досліджень для визначення носійства золотистих стафілококів та патогенних ентеробактерій, та більше 3000 паразитологічних аналізів. Крім того, у планових науково-дослідних і дисертаційних робіт.

Проводиться співпраця кафедри мікробіології, вірусології та імунології з бактеріологічними лабораторіями Університетської лікарні, по дослідженню полірезистентних штамів бактерій за допомогою бактеріального аналізатора Vitek Compact-2, та моніторинг антибіотикорезистентності чутливості мікроорганізмів до антибіотиків за допомогою систем WHOOLE-net .



